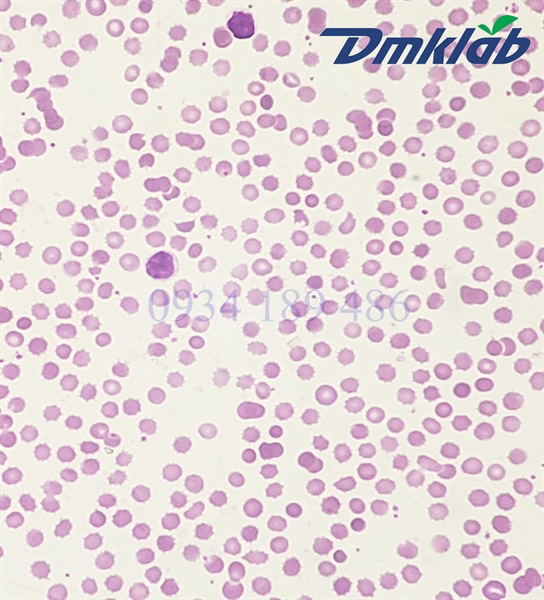

SP001965
Tiêu bản máu thỏ - Cái
120,000đ
Đơn vị tính:
Cái
Mô tả chi tiết
- Đây là tiêu bản hiển vi cố định: là tiêu bản hiển vi mà các tế bào gắn trên đó đã được xử lí qua rất nhiều công đoạn phức tạp như: cố định mẫu; cắt, ép, phết mẫu lên lam kính; đem lam kính đi nhuộm; khử nước; sấy khô mẫu; cố định mẫu vĩnh viễn bằng keo chuyên dụng. Chính vì vậy, tiêu bản hiển vi cố định thường có thời gian sử dụng rất lâu, có những tiêu bản có thể sử dụng lên đến vài chục năm. Tuy nhiên, chất lượng màu sắc của tiêu bản sẽ giảm đi theo thời gia. Thường thời gian sử dụng tốt nhất là 3-5 năm. Các bạn nên thay tiêu bản mới nếu thấy chất lượng tiêu bản không còn như ban đầu.
- Màu tế bào nhuộm đẹp, màu tiêu bản đậm và rõ nét, dễ dàng quan sát. Đặc biệt tiêu bản chúng tôi cung cấp có độ bền cao vì đã được gắn lam phủ để bảo vệ mẫu.
- Màu tế bào nhuộm đẹp, màu tiêu bản đậm và rõ nét, dễ dàng quan sát. Đặc biệt tiêu bản chúng tôi cung cấp có độ bền cao vì đã được gắn lam phủ để bảo vệ mẫu.
